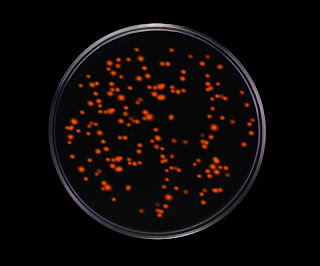

Every artist, scientific or not, has his or her individual style. It's when certain elements of one's style start forming a pattern that makes
Many of you have probably heard of Georgia O'Keeffe. She was an American artist born on November 15th, 1887; she died in the March of 1986. During her extremely long life, she produced a number of interesting paintings. Yes, she also did a few things that merit looking at on this column.
Georgia O' Keeffe was not a scientist. She did, however, do a number of works, most notably flowers. Hyper-detailed, fully-colored macro shots of flowers. She also did a lot of images of New Mexico, but the flowers are more common in art museums. Gee, I wonder why?
In stark contrast to the innocence of flowers, O'Keeffe also painted a lot of skulls. She has images of stag, ram, and bull skulls floating over New Mexico, a setting that she was obsessed with. Sometimes, as if to hint at a certain something, she even did skulls alongside flowers. Eros and Thanatos were at home in one piece...but what if there was a deeper connection?
The creepy thing is why she did bull skulls alongside flowers. The answer, it turns out, is purely scientific:
Flowers and skulls are both....feminine. A flower looks like a vulva; an ungulate skull, the inner workings of the feminine reproductive system. Given that skulls are outstanding in O'Keeffe's work, she must have known about that relationship. It's creepy, but at the same time amazing.If this were not a clearly intentional relationship, I would not be pointing it out here.
The strange thing is how I came about this revelation. There was once a book called The Alphabet Versus the Goddess, which equated alphabets with masculinity and left-brain thinking. Much of the book is a pile of bullplop as far as learning about writing systems is concerned, but how it was written shows that the book was written by a surgeon. He found the relationship between Cretan bull worship and the feminine reproductive tract easily. That one little grain was the best part of the entire book; now you don't have to buy it, and you got to enjoy some trippy art for the new year. :)
But enough morbidity. On with Freak Week 4!
Many of you have probably heard of Georgia O'Keeffe. She was an American artist born on November 15th, 1887; she died in the March of 1986. During her extremely long life, she produced a number of interesting paintings. Yes, she also did a few things that merit looking at on this column.
 |
| "Flower of Life II." Remember that title. |
Georgia O' Keeffe was not a scientist. She did, however, do a number of works, most notably flowers. Hyper-detailed, fully-colored macro shots of flowers. She also did a lot of images of New Mexico, but the flowers are more common in art museums. Gee, I wonder why?
In stark contrast to the innocence of flowers, O'Keeffe also painted a lot of skulls. She has images of stag, ram, and bull skulls floating over New Mexico, a setting that she was obsessed with. Sometimes, as if to hint at a certain something, she even did skulls alongside flowers. Eros and Thanatos were at home in one piece...but what if there was a deeper connection?
The creepy thing is why she did bull skulls alongside flowers. The answer, it turns out, is purely scientific:
Flowers and skulls are both....feminine. A flower looks like a vulva; an ungulate skull, the inner workings of the feminine reproductive system. Given that skulls are outstanding in O'Keeffe's work, she must have known about that relationship. It's creepy, but at the same time amazing.If this were not a clearly intentional relationship, I would not be pointing it out here.
The strange thing is how I came about this revelation. There was once a book called The Alphabet Versus the Goddess, which equated alphabets with masculinity and left-brain thinking. Much of the book is a pile of bullplop as far as learning about writing systems is concerned, but how it was written shows that the book was written by a surgeon. He found the relationship between Cretan bull worship and the feminine reproductive tract easily. That one little grain was the best part of the entire book; now you don't have to buy it, and you got to enjoy some trippy art for the new year. :)
But enough morbidity. On with Freak Week 4!